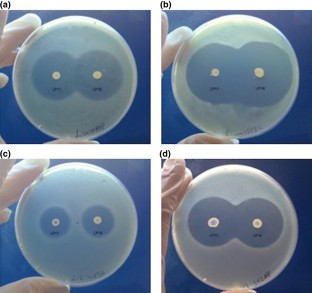

Abstract
This study addressed the bacteriocin production in 116 lactic acid bacteria isolated from 143 fish and seafood samples. The screening for the production of antibacterial substances allowed for the selection of 16 LAB isolates endowed with inhibitory capability. Bacteriocins (bacLP17 and bacLP18) of two strains, Enterococcus mundtii LP17 and Enterococcus mundtii LP18, respectively, isolated from red mullet and sardine samples, determined large inhibition zones against all the Listeria species. Virulence traits and antibiotic resistances of all producers were verified, and no isolates presented dangerous characteristics, including the two best bacteriocin producers E. mundtii LP17 and E. mundtii LP18, which were subsequently investigated for their potential use in fish and seafood products biopreservation. For both strains, the highest level of bacteriocin production (1280 AU/ml) was recorded when cells were grown at 30 °C in MRS broth at pH ranging from 6.0 to 9.0, and high levels of adsorption of bacteriocins, bacLP17 and bacLP18, to the target cells Listeria monocytogenes were also observed. The results obtained in this study revealed that two strains of E. mundtii originating from seafood exhibited a strong inhibitory activity against L. monocytogenes and may be useful in controlling the growth of this pathogen in the same food products.

Similar content being viewed by others
References
Buchanan RL, Gorris LGM, Hayman MM, Jackson TC, Whiting RC (2017) A review of Listeria monocytogenes: an update on outbreaks, virulence, dose-response, ecology, and risk assessments. Food Control 75:1–13
Ericsson H, Ekløw A, Danielsson-Tham ML, Loncarevi S, Mentzing LO, Persson J et al (1997) An outbreak of listeriosis suspected to have been caused by rainbow trout. J Clin Microbiol 35:2904–2907
Brett MSY, Short P, McLauchlin J (1998) A small outbreak of listeriosis associated with smoked mussels. Int J Food Microbiol 43:223–229
Tham W, Ericsson H, Loncarevic S, Unnerstad H, Danielsson-Tham ML (2000) Lessons from an outbreak of listeriosis related to vacuum-packed gravad and cold-smoked fish. Int J Food Microbiol 62:173–175
Ghanbari M, Jami M (2013) Lactic acid bacteria and their bacteriocins: a promising approach to seafood biopreservation. In: Kongo WM (ed) Lactic acid bacteria - R & D for food, health and livestock purposes. InTechOpen, Rijeka
Calo-Mata P, Arlindo S, Boehme K, de Miguel T, Pascoal A, Barros-Velazquez J (2008) Current applications and future trends of lactic acid bacteria and their bacteriocins for the biopreservation of aquatic food products. Food Bioprocess Technol 1:43–63
Kekessy DA, Piguet JD (1970) New method for detecting bacteriocin production. Appl Microbiol 20:282–283
Rogers AM, Montville TJ (1991) Improved agar diffusion assay for nisin quantification. Food Biotechnol 5:161–168
Gatti M, Fornasari ME, Nevian E (1997) Cell-wall protein profiles of dairy thermophilic lactobacilli. Lett Appl Microbiol 25:345–348
Bover-Cid S, Holzapfel WH (1999) Improved screening procedure for biogenic amine production by lactic acid bacteria. Int J Food Microbiol 53:33–41
CLSI. Clinical and Laboratory Standards Institute (2015). M100-S25 Performance Stand. Antimicrob. Susceptibility Test. Twenty-Fifth Informational Suppl. Wayne PA CLSI Clin. Lab. Stand. Inst
European Food Safety Authority (EFSA) (2012) Guidance on the assessment of bacterial susceptibility to antimicrobials of human and veterinary importance. EFSA J 10(6):2740
Mayr-Harting A, Hedges AJ, Berkeley RCW (1972) Methods for studying bacteriocins. Methods in microbiology. Academic Press, Massachusetts, pp 315–422
Yang R, Johnson MC, Ray B (1992) Novel method to extract large amounts of bacteriocins from lactic acid bacteria. Appl Environ Microbiol 58:3355–3359
Yildirim Z, Avsar YK, Yıldırım M (2002) Factors affecting the adsorption of buchnericin LB, a bacteriocin produced by Lactocobacillus buchneri. Microbiol Res 157:103–107
Ahmadova A, Todorov SD, Choiset Y, Rabesona H, Mirhadi Zadi T, Kuliyev A et al (2013) Evaluation of antimicrobial activity, probiotic properties and safety of wild strain Enterococcus faecium AQ71 isolated from Azerbaijani Motal cheese. Food Control 30(2):631–641
Todorov SD, Botes M, Danova ST, Dicks LMT (2007) Probiotic properties of Lactococcus lactis ssp. lactis HV219, isolated from human vaginal secretions. J Appl Microbiol 103(3):629–639
Pingitore EV, Todorov SD, Sesma F, de Melo Franco BDG (2012) Application of bacteriocinogenic Enterococcus mundtii CRL35 and Enterococcus faecium ST88Ch in the control of Listeria monocytogenes in fresh Minas cheese. Food Microbiol 32(1):38–47
Schelegueda LI, Vallejo M, Gliemmo MF, Marguet ER, Campos CA (2015) Synergistic antimicrobial action and potential application for fish preservation of a bacteriocin produced by Enterococcus mundtii isolated from Odontesthes platensis. LWT—Food Science and Technol 64(2):794–801
Jensen MA, Webster JA, Straus N (1993) Rapid identification of bacteria on the basis of polymerase chain reaction-amplified ribosomal DNA spacer polymorphisms. Appl Environ Microbiol 59(4):945–952
Tyrrell GJ, Bethune RN, Willey B, Low DE (1997) Species identification of enterococci via intergenic ribosomal PCR. J Clin Microbiol 35(5):1054–1060
Gueimonde M, Sanchez BG, de Los Reyes-Gavilán C, Margolles A (2013) Antibiotic resistance in probiotic bacteria. Front Microbiol 4:202
Lahtinen S, Ouwehand AC, Salminen S, Wright A (2012) Lactic acid bacteria: microbiological and functional aspects. CRC Press, Taylor & Francis, Boca Raton
Gatesoupe FJ (2008) Updating the importance of lactic acid bacteria in fish farming: natural occurrence and probiotic treatments. J Mol Microbiol Biotechnol 14(1–3):107–114
Ghanbari M, Jami M, Domig KJ, Kneifel W (2013) Seafood biopreservation by lactic acid bacteria—a review. LWT—Food Science and Technol 54:315–324
Feldhusen F (2000) The role of seafood in bacterial foodborne diseases. Microbes Infections 2(3):1651–1660
Pilet M, Leroi F (2010) Applications of protective cultures, bacteriocins and bacteriophages in fresh seafood and seafood products. In: Lacroix C (ed) Protective cultures, antimicrobial metabolites and bacteriophages for food and beverage biopreservation. Woodhead Publishing, Sawston, pp 1–2
Beaufort A, Rudelle S, Gnanou-Besse N, Toquin MT, Kerouanton A, Bergis H et al (2007) Prevalence and growth of Listeria monocytogenes in naturally contaminated cold-smoked salmon. Lett Appl Microbiol 44(4):406–411
Hu Y, Gall K, Ho A, Ivanek R, Gröhn YT, Wiedmann M (2006) Daily variability of Listeria contamination patterns in a cold-smoked salmon processing operation. J Food Prot 69(9):2123–2133
Author information
Authors and Affiliations
Corresponding author
Additional information
Publisher's Note
Springer Nature remains neutral with regard to jurisdictional claims in published maps and institutional affiliations.
Rights and permissions
About this article
Cite this article
Iseppi, R., Stefani, S., de Niederhausern, S. et al. Characterization of Anti-Listeria monocytogenes Properties of two Bacteriocin-Producing Enterococcus mundtii Isolated from Fresh Fish and Seafood. Curr Microbiol 76, 1010–1019 (2019). https://doi.org/10.1007/s00284-019-01716-6
Received:
Accepted:
Published:
Issue Date:
DOI: https://doi.org/10.1007/s00284-019-01716-6




